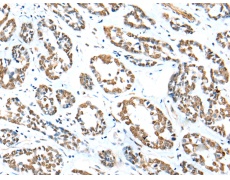
一抗

中文名稱:兔抗ZNF248多克隆抗體
技術(shù)規(guī)格
Background:
ZNF248 belongs to the krueppel C2H2-type zinc-finger protein family. It contains 8 C2H2-type zinc fingers and 1 KRAB domain. ZNF248 may be involved in transcriptional regulation.
Applications:
ELISA, IHC
Name of antibody:
ZNF248
Immunogen:
Full length fusion protein
Full name:
zinc finger protein 248
Synonyms:
bA162G10.3
SwissProt:
Q8NDW4
ELISA Recommended dilution:
5000-10000
IHC positive control:
Human esophagus cancer and Human thyroid cancer
IHC Recommend dilution:
20-100

 購物車
購物車 幫助
幫助
 021-54845833/15800441009
021-54845833/15800441009